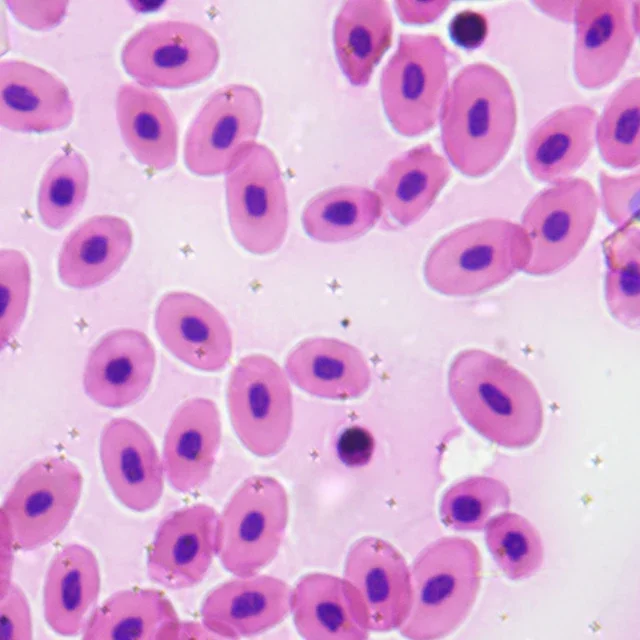
thumb

BHC3E-1080P Economical Digital Microscope Camera
Price history chart & currency exchange rate
Customers also viewed

$100.28
Odontography; or, A Treatise on the Comparative Anatomy of the Teeth; Their Physiological Relations, Mode of Development, and Microscopic Structure, in the Vertebrate Animals Volume; Volume 2
bambook.com
$97.79
CF Grow 210W LED Grow Light Full Spectrum Hydroponic Plant Growing Lamp for Indoor Greenhouse Tent Flowers Fruit Growth Lighting
aliexpress.com
$12.80
Шлепанцы женские с бантом, милые шелковые туфли без застежки, заостренный носок, низкий каблук, сланцы, уличные тапочки для девушек, весна 2022
aliexpress.ru
$16.58
Women High Waist Knitted Skirts New Arrival 2021 Spring Autumn Korean Simple Style All-match Ladies Casual Pencil Skirts W039
aliexpress.com
$4.79
Демисезонные леггинсы для девочек, брюки, новинка, детские брюки, одежда для девочек, детские разноцветные полоски
aliexpress.ru
$13.98
Women Cosmetic Bag Blue Ethnic Koi Fish Make Up Organizer Bag Travel Cosmetic Case for Female Storage Toiletry Bag
aliexpress.com
$11.05
Adhesive Instrument Pickup with 1/4 inch Jack 3.0M Cable for Guitar Violin Mandolin Ukulele
aliexpress.com
$0.53
Hot BT-168 PRO AA/AAA/C/D/9/1.5V batteries Universal Button Cell Battery Colour Coded Meter Indicate Volt Tester Checker Power
aliexpress.com
$6.46
Поплавок овальной пробки, пенопластовый космический боб, рыболовный поплавок, пробка для лески, поплавок с семью звездами L Red
joom.com
$91.68
Мужская деловая рубашка с длинным рукавом и геометрическим рисунком на пуговицах Azaro Uomo, синий
cdek.shopping
$20.95
Настоящие автомобильные аксессуары из углеродного волокна, набор панелей переключения передач, мягкая наклейка, наклейка для Chevrolet Impala 2000 2001 2002 2003 2004
aliexpress.ru
$23.26
100 Вт пылесборник для ногтей 4500 об/мин съемный фильтр-экран пылесос для ногтей с подушкой для рук
aliexpress.ru
$4.10
4 шт., подставка для практики дизайна ногтей, стабильная базовая конструкция, изготовленная из смолы, легко чистится, подходит для профессиональных индивидуальных акриловых ногтей
aliexpress.ru
$17.94
AD35 Звукосниматель для классической народной акустической гитары со звуковой панелью, укулеле, инструментом guzheng
aliexpress.ru
$86.02
Мужские повседневные ботинки из натуральной кожи, удобные дышащие мужские кроссовки, зимние высокие меховые теплые ботильоны, модная мужская обувь 44 бежевый
joom.com
$125.46
Подвесной светильник для гостиной с полной защитой глаз, в стиле ретро, роскошный и грандиозный, осветительные приборы для загородного дома, светильники для спальни и столовой 5 headlights
joom.com
$64.77
Akaaka Child Car Seat Protective Car Seat Cover with Extra Thick Waterproof and and Storage Pocket Mat, Cushion, Stain-Resistant, (Black) чёрный
joom.com
$25.09
Овощерезка, слайсер, лезвия из нержавеющей стали, многофункциональный кухонный гаджет для быстрого приготовления еды синий
joom.com
$12.30
Женская шляпа осень-зима художественная ретро универсальная замшевая бархатная шляпа модная восьмиугольная шляпа японская рыбацкая шляпа One size чёрный
joom.com
$91.46
Весенняя однотонная простая свободная куртка с воротником-стойкой, мужская повседневная куртка в корейском стиле с буквенным принтом, универсальное пальто, модная толстовка 3XL
joom.com
$68.58
Baby Float for with Cute Super Sports Baby Prevents Summer For Water Outdoor Kids, Foot-In Type, Handle, Print, Car, Float, Toy, Capsizing, Days, синий
joom.com
$55.80
Женские туфли на плоской подошве, удобные мокасины, женские дышащие кожаные кроссовки на шнуровке, женские модные черные повседневные туфли для женщин 35 чёрный
joom.com
$7.32
4.8CM*25M Caution Signs Adhesive Tape Yellow Tape Danger Identification Tape Universal 2-THANK YOU
joom.com
$50.97
Цветовая гамма обуви Dexun женская 2025 лето новая удобная на плоской подошве одинарная обувь модная универсальная сетчатая дышащая мягкая подошва повседневная 40 фиолетовый
joom.com
$96.31
Огнеупорный и водостойкий чехол для документов Octantis с кодовым замком, 36×27×10,5 см, большая вместимость чёрный
joom.com
$39.05
Retro diamond embroidered thread handbag bag women s new trend women s bag high-end texture shoulder messenger bag белый
joom.com
$27.91
Мужская бейсболка Four Seasons, повседневная, состаренная, из выстиранного хлопка, с вышивкой букв, с изогнутым козырьком, куполообразная, повседневная шляпа для защиты от солнца
joom.com
$25.16
Applicable To Apple 16 Metal Paint Frameless Magnetic Suction Phone Case IPhone 15 Ultra Thin Bare Metal Sense Anti Fall Protection Case iPhone 12 PROMAX
joom.com
$16.60
Большая емкость Складной дизайн Портативная ванночка для ног Таз Расширяемый Легкое хранение Таз для замачивания ног серый
joom.com
$74.02
Повседневная бейсбольная куртка в стиле хип-хоп, приталенная нейтральная бейсбольная форма, куртка-бомбер, мужская молодежная трендовая одежда для колледжа, осенняя одежда XL синий
joom.com
$7.17
3 сетки настенный мешок для хранения Организатор игрушки контейнер декор карманный мешок ГОРЯЧИЙ
joom.com
$8.71
Мужские цифровые часы, водонепроницаемые, противоударные, с силиконовым ремешком, спортивные часы для подростков, студентов, активного отдыха
joom.com
$10.85
День свадьбы, день рождения, цветочная бумажная корзина, упаковочная коробка для цветов, подарочная коробка с цветами, упаковочная сумка с розой красный
joom.com
$7.84
Велоаксессуары Электровелосипед Звуковой сигнал Реверсивный голосовой сигнал Звуковой сигнал для трехколесного велосипеда Противоугонный реверсивный голос 3in1
joom.com
$9.01
Измерительный инструмент из нержавеющей стали с прямым углом, линейка с поворотом на 90 градусов, деревообработка 02-15CM
joom.com
$31.32
CD LENNY CARLSON - Search For The Floor AIRAC1020 Air Mail Archiv 2002 Japan Jazz Used
joom.com